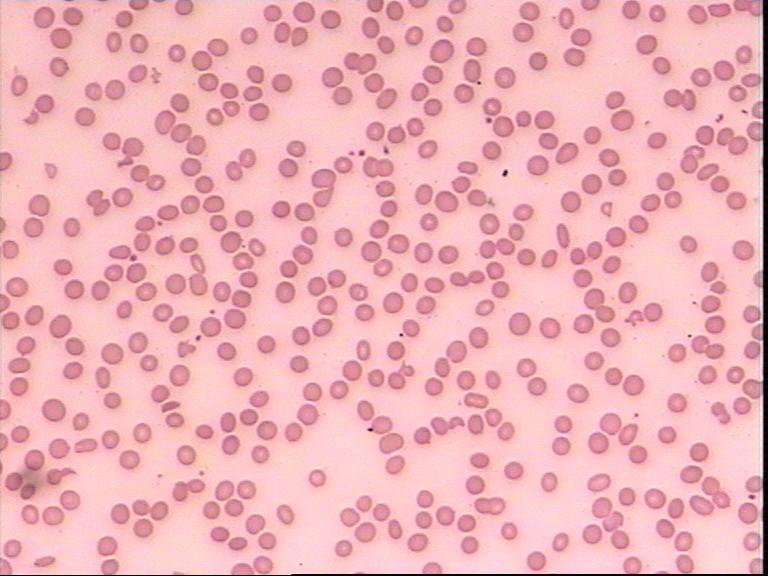
胆囊结石超声检查是常见的假阳性,遗传性球形红细胞增多症胆结石
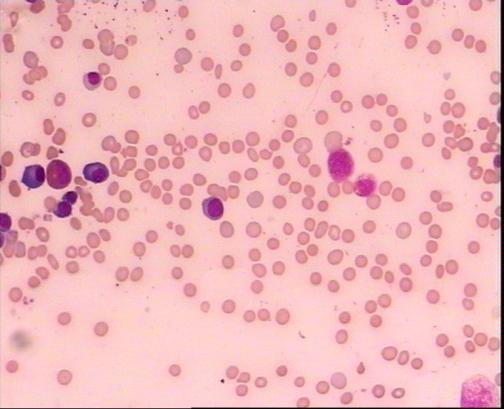
胆囊结石超声检查是常见的假阳性,遗传性球形红细胞增多症胆结石

广州中医药大学一附院微信订阅号【检视界】专栏,逢周日推送!本栏文章由该院检验科专家亲自撰文或指导写作,内容涉及常见检验项目的科普讲解、检验前的注意事项及检验后的结果解读,实用、权威!敬请关注!
反复胆囊结石,真凶竟是遗传性球形红细胞增多症!
文/检验科 刘基铎 主任技师
反复胆囊结石,3年做了5次胆囊取石手术!
广东深圳的L先生今年34岁。他出生未满1岁时,当时无明显诱因出现右上腹疼痛不适感,以胀痛为主,在当地医院行腹部B超及CT检查提示“胆管结石”,予抗感染等对症治疗后症状缓解,此后腹部疼痛反复出现。
他在28岁那年,被当地医院诊断为“肝内胆囊扩张,胆总管、胆囊结石”,进行了人生中第一次逆行胰胆管造影检查(ERCP)并行取石术,术后腹痛症状缓解。可惜仅过4个多月再次出现腹痛、发热、恶寒,体温最高达到40℃,间断于当地医院对症治疗,病初每月发热1次,后逐渐发展为2-3天发作1次。
术后第9个月他来到省城大医院就诊,腹部CT检查提示:“肝内胆管扩张、胆囊管结石、胆总管下段结石、脾大”,再次行ERCP取石、抗感染治疗,治疗后病情仍反复。多次就诊于广东省内各大医院及香港特区医院,在三年内做了5次ERCP治疗。此后两年被病痛折磨的L先生决定远赴首都寻求治疗,先后在两家国内顶尖医院求治,经过检查考虑硬化性胆管炎可能;肝硬化改变;脾大,脾门及胃底静脉曲张,胆囊泥沙样结石。拒绝手术治疗的L先生,经过药物治疗后有所缓解,症状好转出院。但很快出现间断发热,右上腹胀痛,无奈的L先生为寻求中医治疗,就诊我院消化内科并入院治疗。
这时的L先生主要不适是右上腹疼痛,并出现肝硬化,伴腹水,巨脾(肋下10厘米),血液分析示白细胞总数3.12X10e9/L,血红蛋白量69g/L,血小板总数88X10e9/L;凝血功能:血浆凝血酶原时间20.0秒、国际标准化比率1.66、活化部分凝血活酶时间43.6秒、血浆纤维蛋白原4.54g/L;生化指标:白蛋白26.2g/L,总胆红素29.5umol/L,直接胆红素13.7umol/L,球蛋白51.7g/L。影像学结果:胆囊结石可能,胆囊炎,胆总管结石,肝内胆管节段样扩张,胆总管近肝门狭窄,管壁增厚,考虑硬化性胆管炎可能;肝硬化改变;脾大,少量腹水,脾门及胃底静脉曲张。
辗转数十载终遇明医,擒出真凶!
临床医生认为患者病情较复杂,诊断尚不明确,尤其患者反复出现胆道结石原因不确定,结石的性质亦不明确。由于血液分析出现白细胞、红细胞及血小板三系细胞减少,为排除血液系统疾病,临床医生给L先生查了外周血细胞形态并抽取骨髓做检查。
作者刘医生在外周血细胞形态学检查发现L先生存在大量球形红细胞(如图1),球形红细胞比例约占70%多。
外周血瑞氏染色放大200倍
骨髓涂片检查亦发现成熟红细胞中存在大量球形红细胞(见图2),并有幼稚红细胞明显增生,中、晚幼红细胞比例增高。
骨髓细胞涂片瑞氏染色放大200倍
外周血及骨髓形态都很明确支持球形红细胞增多症,加做红细胞渗透脆性试验,结果红细胞对低渗盐水不耐受,渗透脆性增高,符合球形红细胞增多症改变。为了证实是否属于遗传性球形红细胞增多症,我们对L先生进行了家系调查,L先生有兄长两人,无姊妹,大兄长早年因胆道反复感染死亡。L先生父母亲及另一兄长均进行外周血细胞形态学检查,结果发现其父亲及兄长外周血中分别有约30%及40%的球形红细胞存在,母亲成熟红细胞形态大致正常。结合其临床症状、体征及家庭史,考虑为遗传性球形红细胞增多症,并进行了脾脏切除手术,术后症状明显得到缓解。
一个简单的仅二十多元的外周血细胞形态检查,助我们找到令L先生深受反复胆石症困扰的真凶,让痛苦多年、濒临绝望的他获得新生!
什么是遗传性球形红细胞增多症?
遗传性球形红细胞增多症是红细胞膜有先天缺陷的一种溶血性贫血,主要表现为贫血、黄疸、脾肿大,诊断依据是血液中球形红细胞增多。正常红细胞的形态是呈盘状且中间凹陷的,当红细胞的形态发生改变时可引起贫血。这种病是常染色体显性遗传病,男女都可发病,每代都会有发病者。超过一半的遗传性球形红细胞增多症有胆红素性胆囊结石症,10-30岁之间发病率最高。它的诊断除临床症状及体征外,主要诊断手段就是依靠显微镜观察到球形红细胞存在。
作者简介

刘基铎,主任技师,血液病诊断专家,检验科血液专业组负责人,擅长运用细胞形态学、细胞遗传学及流式细胞仪等手段进行血液病诊断,主持及参加省自然科学基金、省科技厅等项目9项,以第一作者在国内核心期刊发表专业论文16篇。社会兼职:中国合格评定委员会技术评审专家,中国抗癌协会血液肿瘤专业委员会中国临床流式联盟第一届委员会委员,广州市医学会医疗事故鉴定专家,广东省中西医结合学会医学实验室自动化专业常务委员,广东省临检血液专家组成员。
编辑:刘庆钧
复核:郑小英、杨艳责编:冯殷
审定:方宁
